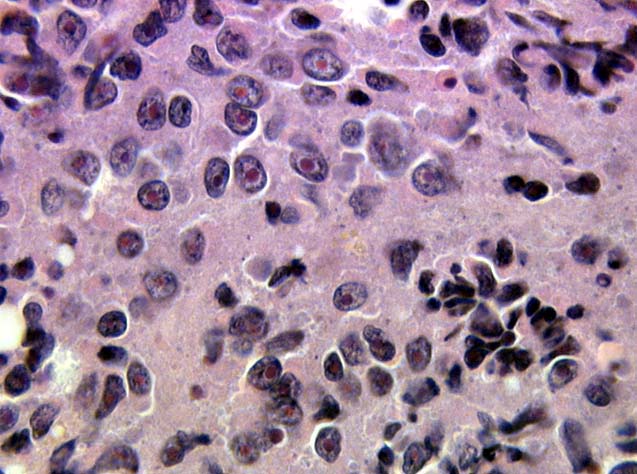

Leucemie A Plasmocytes Pronostic
La 10phase asymptomatique nest diagnostiquee que par un examen systematique.

Leucemie a plasmocytes pronostic. Le signe biologique essentiel est lexistence dune hyperprotidemie responsable dune acceleration de la vs due a une augmentation dune immunoglobuline. Le myelogramme etudie les cellules de la moelle osseuse prelevees par ponction a la recherche dun exces de plasmocytes. Dans le myelome la moelle est. Le myelogramme est une etude cytologique de la moelle osseuse.
Lexamen se fait a partir de liquide medullaire preleve par ponction. 1 le myelome a chaines legeres. Leur diagnostic est difficile en raison de labsence frequente delevation de la. 6 signes osteoarticulaires revelateurs.
Les manifestations osseuses resultent dune augmentation de lactivite osteoclastique au contact des plasmocytes. 1 evolution non compliquee en 3 phases.